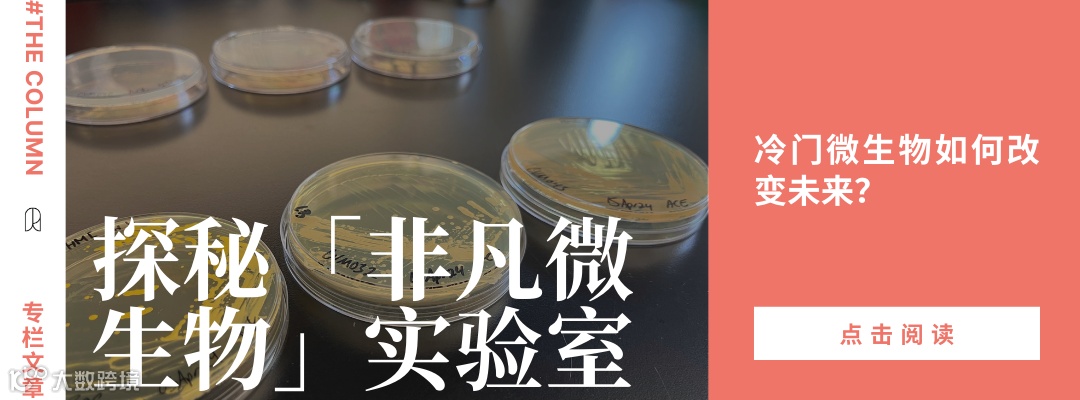

2000年,Michael Elowitz 和他的导师 Stanislas Leibler 构建了一个看似简单到无关紧要的东西——一个由仅仅三个基因组成的微型基因电路。他们称之为"Repressilator"(压缩振荡子),它让细菌像霓虹灯一样闪烁。
但这不仅仅是个炫酷的小把戏,而是一个概念验证:我们真的可以像编程计算机一样编程细胞。
时间快进到今天,合成生物学正成为 21 世纪最具变革性的领域之一。而压缩振荡子正是其中最早的蓝图之一。它的诞生是为了回答一个问题:细胞究竟是如何运作的? 这篇采访带你回到那个时刻,一个从物理学跨界到生物学的科学家,开始亲手“调试”生命本身。
——Asimov Press 中国团队

引 言
1997 年,Michael Elowitz 在普林斯顿大学攻读物理学博士学位时,萌生了一个非同寻常的想法:如果能够用 DNA 而非电子元件来构建电路,并利用它来“编程”活细胞,会怎样?
在接下来的三年里,Elowitz 与导师 Stanislas Leibler 合作,专注于合成基因电路(synthetic gene circuit)的研究,并最终实现了这一构想。他的最终设计——如今被称为“压缩振荡子”(Repressilator),仅由三个基因构成,每个基因编码一种抑制子蛋白(repressor protein),该蛋白会阻止下一个基因的转录,从而形成一个循环。
例如,LacI 抑制控制 TetR 表达的启动子(promoter),TetR 蛋白抑制控制 cI 表达的启动子,而 cI 又抑制控制 LacI 表达的启动子。此外,一个绿色荧光蛋白(GFP) 基因被放置在其中一个启动子旁边,随着工程化细胞依次切换基因表达状态,它们会呈现交替闪烁的绿光——黑暗——绿光——黑暗。就这样,Elowitz 成功地创造出了作为活体振荡器(living oscillators)运作的细胞。
2000 年,Elowitz 的研究成果在《自然》(Nature)杂志上发表,与其同一期刊登的还有另一项关于合成基因电路的研究——“拨动开关(toggle switch)”线路。这两篇论文成为了一个崭新科学领域——合成生物学(synthetic biology)的标志性研究。
这些早期的合成基因电路表明,科学家们确实可以重构活细胞内复杂的基因网络,并通过操控这些网络,让细胞执行全新的功能。换句话说,人类可以“编程”生物学。
如今,Elowitz 是加州理工学院(Caltech)生物学、生物工程与应用物理学的教授。近期,他接受了 Asimov Press 的访谈。在这次对话中,他回顾了自己在研究压缩振荡子过程中曾有的疑虑,探讨了物理学家对生物学研究所带来的独特思维方式,并分享了他团队近期的研究进展——包括已发表和未发表的工作——致力于开发技术,以解码生命机制。
本篇访谈已经过编辑,以确保内容简洁清晰。

>登录 press.asimov.com 输入邮箱成为订阅会员<

Michael Elowitz 在显微镜前的近照。图片来源:Yitong Ma/David Jacobson。
访 谈
我有点不好意思用压缩振荡子(repressilator)来开场这个采访。大家肯定都会问你关于它的事情。但当我把你的论文和“拨动开关”(toggle switch)的论文放在一起对比时,我注意到了一点,想向你请教。你的论文讨论部分强调了合成基因电路在解析自然然生物系统中的重要性,而另一篇论文则更多关注其商业潜力。你能详细谈谈这个吗?
嗯,我研究合成生物学的动力更多来自基础研究,将其作为探索细胞工作机制的一种方式。但我也一直想探究一个问题——我们是否真的可以像编程计算机一样编程细胞? 这个想法对我来说非常有吸引力。
然而,在最初的几年里,实验室里的所有工作都非常缓慢且困难。即使是构建压缩振荡子,它只有三个基因,以今天的标准来看似乎是一个微不足道的系统,但当时我花了好几年才完成。我必须逐个表征每个转录单元(characterize each transcription unit),并尝试设置一种方法,使我能够独立测量每个抑制子对下一个的传递函数(set it up in a way where I could measure each transfer function from one repressor to the next independently),然后再将它们串联成两步基因反应(concatenate them into two gene steps),依此类推。
2000 年的那期《自然》(Nature)发表后,合成生物学迅速兴起。你如何看待这一领域的快速发展?
起初,这一领域的发展主要是由为数不多但数量不断增长的实验室主导的,他们迈出探索的第一步,循序渐进地实现新的生物功能,比如数字逻辑(digital logic)、计算(computation)、群体感应(quorum sensing)等。这些微小的进步为后来的更复杂能力奠定了基础。
但我始终相信“编程细胞(programming cells)”的愿景,并且意识到,要真正实现这一目标,我们还需要掌握更多基础知识。要让我们的基因电路真正发挥作用,并使它们能够利用细胞的核心功能,我们必须弄清楚各种细胞系统的“API”(应用程序接口)——比如转录(transcription)、信号传导(signaling)、细胞周期(cell cycle)等等。同时,我们还需要弄清楚一些系统行为的基本方面,这些方面尚未在定量水平或单细胞水平上被测量。
举个例子,在压缩振荡子论文发表后不久,我又开展了一项研究,测量一个简单的响应函数(response function)——即抑制子对其靶基因的定量影响。这个函数的形态和波动性对于预测更大规模的转录电路如何运行至关重要。这项研究是我与 Nitzan Rosenfeld、Jon Young、Uri Alon 和 Peter Swain 合作完成的。
与此同时,尽管这些真实且对我来说非常激动人心的实验正在进行,并且有一小部分但不断增长的实验室在发表有趣的论文,合成生物学却被大肆炒作起来。这种炒作似乎超出了该领域当时的实际发展水平。由于我本身性格比较焦虑,我当时还很担心,如果整个领域承诺了无法在合理时间内兑现的事情,这种炒作最终可能会反噬我们自己。不过,现在回过头来看,这种担忧其实是多余的。
你提到“细胞的 API”,能具体解释一下你的意思吗?
我指的是合成电路能够控制自然细胞功能的生化接口(biochemical interfaces through which natural cellular functions can be controlled by synthetic circuits)。最直观的例子就是转录和翻译,因为它们可以用于表达任何目标基因。但合成电路的能力不仅仅取决于这些基本过程,而是取决于它们能否控制尽可能多的内源性功能(endogenous functions),例如:细胞周期,细胞生长,形态状态变化(morphological states),细胞间通讯,细胞凋亡(death programs,死亡程序),细胞成分的输出。然而,这些细胞系统究竟如何能被合成电路以特定方式控制,同时又不干扰其它生物过程,往往并不清楚。因此,发现这些控制点——即定义细胞的天然 API——是合成生物学中的一个重要方面。
压缩振荡子的想法最早是怎么来的?
这应该是在 1996 或 1997 年。我当时是普林斯顿大学 Stanislas Leibler 实验室的研究生。实验室里有很多人在研究不同的生物回路模型,比如趋化性(chemotaxis)。那段时间,我阅读了大量关于分子生物学的论文,特别是关于生物钟(circadian clocks)的研究。此外,我还读了一本书,叫《生物反馈》(Biological Feedback),作者是 Thomas 和 D’Ari,这本书勾勒出了各种反馈回路的简单模型。
当我阅读这些论文时,我注意到其中许多都以一个示意性的生物回路模型作为结尾,这个模型是基于论文中的遗传或生化测量推导出来的(a cartoon model of the biological circuit deduced from the genetic or biochemical measurements in the paper)。我最深刻的感受是:这些回路示意图真的足以解释这种生物行为吗?还是说,它们只是对观察到的相互作用的一个总结,可能遗漏了许多关键的组成部分? 这让我感到非常困惑。
比如说,我们怎么能确定一个特定的相互作用和成分组合就足以解释某种细胞行为呢?如果你从自上而下(top-down)的方式研究回路,你无法确定自己有没有遗漏关键成分。但如果你从零开始搭建一个回路(build the circuit up from scratch),完全由已知的、定义明确的组件和相互作用构建而成,那么你就可以真正测试这个回路是否足以驱动某种特定的行为。
所以,这就是我的想法。 我想要直接构建一个基因回路,看看它是否能够执行某种特定的行为。压缩振荡子正是来源于这个宏大的目标。至于为什么我选择振荡器而不是其它类型的回路,这与我在物理学中研究过的各种振荡器、我阅读过的生物钟研究,以及最重要的一点——我可以制作“会闪烁的细菌”电影(cool movies of blinking bacteria)——都有关系。 我当时觉得,如果能创造一个“会闪烁的”基因回路,那将是件超级酷的事。
在这段视频中,由于压缩振荡子的作用,正在生长的大肠杆菌(E. coli)微菌落中的单个细胞会“闪烁”明暗交替。视频来源:Elowitz Lab
这个回路的名字“压缩振荡子(Repressilator)”,一开始就是这个名字吗?
其实直到 1999 年,我一直叫它“Oscillon”,这个名字是 Oscillator(振荡器)和 Operon(操纵子)的合成词。但有一天,我看到一本《自然》(Nature)杂志的封面上印着“Oscillons observed!”(发现 Oscillon!)之类的话。
在那篇文章中,“Oscillon”指的是颗粒介质中的一种相干振荡模式(a coherent oscillatory mode of granular media)。当时我的反应是:“哦,糟糕,这个名字被占用了。”不过现在回头看,我反而很庆幸,因为“Repressilator” 这个名字更棒!它不仅读起来很有趣,还与一系列以城市命名的非线性动力学化学振荡模型相呼应,比如“Brusselator”(布鲁塞尔振荡器)、“Palo Altonator”(帕洛阿尔托振荡器)等等。
在你尝试构建压缩振荡子时,你对这个项目有什么想法?周围的人又是怎么评价的?
说实话,我完全不确定这个项目是否会成功。我不停地问别人对这个想法的看法,结果得到的反馈截然不同。一些知名的生物学家会直接说:“不,这根本行不通。它不会成功。”
我会追问:“为什么它不会成功?”他们则回答:“生物学并不是这么运作的,你无法预测会发生什么。”但也有一些人觉得这个想法很有趣,所以总体来说,反馈是正反参半的。回头来看,这一切都挺有趣的。当时,我对这个项目特别兴奋,到处和人讨论,但又让他们发誓保密。现在想想,真的很搞笑。
与此同时,我的导师 Stanislas Leibler——一位极具远见的科学家,同时也是我个人的灵感来源——始终支持这个项目。我对此一直心存感激。
实际上,我是在 1998 年构建压缩振荡子的,当时 Stan 正在德国海德堡的欧洲分子生物学实验室(EMBL)做学术休假。在那一年里,我一直在寻找最合适的基因调控元件。Hermann Bujard 曾深入研究过细菌启动子(bacterial promoters)的特性,他发现有些启动子可以同时具备强表达和高精确调控这两大特性,而这正是压缩振荡子所需的核心条件。而且,Bujard 也在海德堡。
所以,Stan 和我一起下山去找他聊天,我们向他展示了压缩振荡子的设计。Bujard 看完后,随口提到他一直想做点别的东西,然后直接画出了一个“拨动开关电路“(toggle circuit)!
哇,真是个巧合!你在 2000 年发表压缩振荡子的论文时,你是否知道它会和波士顿大学的 Timothy Gardner、Charles Cantor 和 Jim Collins 发表的“拨动开关”论文并排刊登?毕竟,你当时应该以为自己是唯一在构建合成基因电路的人吧?
是的,我完全不知道有人在研究“拨动开关”,直到我拿到杂志,翻开一看,才发现那篇论文。
当你终于让压缩振荡子运行起来时,你有没有意识到这个时刻的意义?你是否知道自己正在开创一个全新的生物学领域?
其实,在普林斯顿的时候,没有人告诉我“如果你完成这个项目,那就太棒了”。我根本没有得到这样的反馈。但我也没有以这种方式思考问题。我只是觉得:“这会很酷!” 我真的很想知道它到底能不能实现,而且我一直在脑海中想象它运行时的视频。
论文发表后,我做了很多相关的学术报告,大家的反应是积极的。但其实,直到几年后,大概在 2000 年代中期,合成生物学领域才真正迎来爆发式增长。
你发表压缩振荡子论文后,我听说别人很难复现你的实验结果,它有点难以稳定运行。这是真的吗?
我不认为完全是这样。不过,在论文中,我们确实强调了系统的动态变化性(variability in the dynamics)。此外,基础荧光强度(basal fluorescence)随时间增加,这主要是因为我当时采用的实验条件——把细胞培养在琼脂糖凝胶垫上——并不是一个稳态环境。培养基中的代谢废物不断积累,细胞生长速度变慢,从而影响了系统的表现。
几年后,Laurent Potvin-Trottier 和 Johan Paulsson 及其同事们改进了实验方法。他们将原始的压缩振荡子放入了微流控通道中的母机(Mother Machine),通过这种方法,他们能够在恒定条件下跟踪数百代细胞的动态变化。结果发现,压缩振荡子基本上可以无限期地振荡。当然,系统的波动性仍然存在,Laurent 和 Johan 在他们的论文中对此进行了详细解释。
具体是什么原因导致了波动性?
这个结果有点反直觉。原始的压缩振荡子包含三个抑制子,它们依次抑制下一个基因。其中一个关键的抑制子是 TetR,它的特点是结合能力极强。
Johan 发现了一个重要现象:由于 TetR 与操纵子的结合非常紧密,它的抑制作用难以解除。因此,当 TetR 需要解除对目标基因的抑制时,必须等到最后一部分 TetR 分子被稀释出细胞,这个过程极易受到随机波动(stochastic fluctuations)的影响。这种稀释过程的不确定性,实际上是压缩振荡子动态波动的主要来源之一。
Johan 通过优化设计修正了这个问题,最终构建出一个惊人地精准、能够稳定振荡 180 个细胞代的版本。
当人们开始使用“合成生物学”这个术语时,你的想法是什么?你是否觉得,这个领域已经迎来了一个拐点,让你最初担心的炒作如今正逐步成为现实?
我一直很喜欢这个术语,它真的非常贴切。它类似于化学领域的分类方式,比如有机合成化学(synthetic chemistry)和分析化学(analytical chemistry)。
至于合成生物学这个领域,是的,我觉得我们正在迎来拐点。那些极具科幻感的目标仍然遥不可及,但合成生物学能改进或创造有用的治疗方法——并真正利用细胞可编程的能力——这一点正在逐步变成现实。这真的很令人兴奋。
当然,所有的进展都比最初预期的要慢很多。但从根本上讲,细胞在很大程度上确实是一个可编程的装置,这一基本前提似乎是成立的。
细胞是一台计算机吗?或者有更好的类比方式?
计算机类比是一把双刃剑。
从某种角度来看,这种类比是有用的,因为细胞是一个可编程的装置,可以执行多种不同的功能。而在我们的日常生活中,最接近这一概念的东西就是计算机。你可以给计算机编程,让它执行各种任务。同样,你也可以对细胞编程,让它生长、分裂、改变形态、与其他细胞交互,甚至执行许多我们难以想象的复杂功能。细胞是开放式的可编程系统(Cells are open-ended, programmable systems)。
更重要的是,我们甚至可以让细胞执行它在自然进化过程中从未产生过的功能。从这个角度来看,计算机类比是相当准确且有用的。
但是,细胞也有许多方面与计算机不同,我认为这些差异同样重要。细胞是“嘈杂”的(noisy),它们利用这些噪音来控制群体层面的行为。它们还会复制自己并以指数方式增长——计算机是做不到这一点的。细胞的“电路”不是由晶体管和电线连接的,而是由分子之间的特定分子相互作用连接。
另一个例子是负数(negative numbers)。在生物学中不能有负的分子浓度,这意味着生物学必须以独特的方式解决问题。生物系统还有组合性(combinatoriality),它们通过分子组合来编码信号,这些分子竞争形成不同的复合物。这些系统在某些方面类似于数字计算,在其他方面则有所不同。
所以让我对这个比喻感到不安的地方是,当我们开始将电气工程的期望强加于细胞内部那个神秘的世界时。有一些电气工程的原则是适用于活细胞的,但生物学中最有趣的地方,恰恰是它们与计算机的不同之处。

1998 年在德国海德堡举行的实验室讲座幻灯片。图片来源:Michael Elowitz
我最近和 Ed Boyden 交流过,他说了一句话让我印象深刻:“先理解,再增强”(Understand before you augment)。我很好奇,你是否认为我们应该开发一些工具,以更深入地理解细胞,从而让它们变得不那么神秘?在我们能够可靠地编程细胞之前,还有哪些关键问题需要解决?
这是个很棒的问题。我觉得需要解决的东西太多了。我们确实在逐步理解细胞如何调控基因,但连最基本的事情都还做不到——比如,我们甚至无法设计一个可以在所有细胞类型中正常表达的基因。
我们甚至无法在实验室中培养大多数类型的细胞。
没错。此外,我们也无法实时追踪细胞内所有激酶(kinases)的活动,或者类似的动态过程。所以,如果你考虑细胞内部的各种信息层级,它的时空组织方式,然后再看看我们目前能监测和操控的能力,实际上还处于非常原始的阶段。
从系统层面来看,基因递送(delivery)是一个巨大的挑战。我们可以在培养皿中设计出完美的合成基因电路,但如何将这些基因送入细胞仍然是一个难题。因此,我认为这个领域至关重要。
另一个关键问题是免疫原性(immunogenicity)。如果我们开始思考治疗性基因电路,那么如何设计这些元件,使它们不会触发免疫反应,也是一个必须解决的问题。
看起来你的实验室正在开发一些工具和技术,以弥补这些空白。但你们是因为不知道生物学的某些机制,所以才决定开发这些工具?还是说,你们只是跟随自己的兴趣?
两者兼有。很多时候,我们制造工具是因为我们想象出某种东西,并且真的希望它能够存在。RNA 导出器(RNA Exporter)就是一个例子,它是由 Felix Horns 和我实验室的其他人开发的。这个想法来源于这样一个观点:每个人都在研究RNA,观察转录组以及它随时间的变化是很有用的,但这些工具都需要杀死细胞。然而,我们想知道细胞内动态发生了什么,以及如何追踪这些变化。
于是我们设计了一个系统,让细胞将 RNA 包装起来,然后通过细胞外囊泡(extracellular vesicles)分泌出去。通过对从细胞中分泌出来的 RNA 进行测序,可以在不破坏细胞的情况下非破坏性地追踪细胞的动态变化。
RNA 导出器还引出了另一个应用,涉及到基因递送(delivery)问题。我们一直想找到更好的方法将合成基因电路导入细胞,以便将其作为治疗手段。我们想知道,最理想的方式是什么?我们认为,将物质导入细胞的最佳载体就是利用另一种细胞。
我们开始思考,假设我们能够编程让细胞定向到身体的特定部位,识别出那里特定的细胞,然后让这个“递送细胞”(delivery cell)激活,并开始在该位置导出 RNA?导出的RNA可以只转染目标细胞。
因此,RNA 导出器不仅提供了一种随时间追踪 RNA 分子的方式,还为 RNA 的传递提供了一种潜在的方式。
有趣的是,你的研究似乎总是从富有想象力的大问题开始,然后通过这些问题慢慢开发出实用而又非常独特的技术。
是的。当然,我们本可以选择只使用现有的工具,专注于构建生物电路。但我觉得,每当你扩展合成生物学的工具箱时,就会开启新的可能性(But I feel like whenever you expand the toolbox in synthetic biology, it takes you to some interesting places)。
当然,我们无法做所有事情,所以你需要选择专注于哪些工具。很多时候,我的兴趣集中在那些在机制上或美学上都很优雅的事物上:那些优雅的解决方案,将帮助我们迈向一种新的生物学。
最后一个问题:为什么历史上最重要的一些生物学家,往往是物理学家出身?
天真?傲慢?还是相信大自然是可以理解的?我也不知道。但确实,有很多物理学家在生物学领域做出了重要贡献。不过,我觉得我们需要谨慎看待这个问题。许多不同类型的人以不同的方式为生物学做出了贡献。
但这真的只是巧合吗?物理学家在分子生物学的起步阶段至关重要,而在合成生物学的诞生过程中,包括你在内的许多关键人物,也都是物理学家。
我认为,这与物理学的推理方式、思维方式和解决问题的方式有关。物理学家倾向于将问题简化到本质,设想一个问题的最简单例子以及解决它的最简便方法。他们也重视定量方法。如果你回顾最初的合成基因电路,它们的设计原则正是这样——它们真的是任何人能想出的最简单的、但又足以展示关键生物学原理的电路。
但在生物学中,我们不断发现生物系统比我们意识到的要复杂得多。比如,生物学家发现了 TGF-beta 通路,然后又发现它被许多调节因子所调控,而这些调节因子本身又被其它调节因子调控。所以生物学就是一个不断挖掘、不断揭示复杂性的过程。
合成生物学的方法——即“通过构建来理解”(building to understand)——实际上意味着,科学家应该从最简单的电路入手,看看它们能实现什么功能,并在此基础上逐步构建更复杂的系统。我觉得这种方法对物理学家来说很有吸引力,对我个人而言也是如此。但合成生物学和“真实”生物学这两种方法是互补的,我们不希望世界上只存在其中一种方法。
当面对“细胞内的振荡器是如何工作的?”这样的问题时,研究需要从两个方向进行。一方面,我们需要研究人员解析天然振荡器的组成部分,并弄清它们之间的相互作用。另一方面,我们也需要有人提出这样的疑问:“好吧,我们为什么需要这样的复杂性?能够产生这种行为的最小电路是什么?这个最小电路对噪声或温度变化有多敏感?它如何才能更稳健地运行?在细胞中,是否存在振荡器之外的补偿机制,使其保持稳定?”
很多时候,想要真正理解某个系统的运行方式,唯一的方法就是自己去控制其中的相互作用。也就是说,直接构建这个系统,然后观察它的运行情况。我认为这种探索冲动在生物学领域由来已久,只不过直到最近,我们才拥有必要的基因工程工具来真正实现这一点。
引用:
Michael Elowitz. "Synthetic Origins." Asimov Press (2024). DOI: https://doi.org/10.62211/21yr-22te
原文发表于 2024 年 4 月 2 日。
英文原文链接:https://press.asimov.com/articles/synthetic-origins

∗∗∗
如果你想对这篇文章提出问题,以及希望加入 Asimov Press 的中国读者社区,欢迎发送一句话的简介,到联系邮箱:asimovpresschina@163.com,期待与你交流。如果你有具体的问题和合作意向,可以添加个人微信 ID: 2871981198,请附上一句话介绍。期待与你交流。
点击“阅读原文”即可查看英文原文
请星标我们🌟,欢迎点赞+在看+转发!:)
版权声明:Asimov Press 发布的所有内容,包括英文原版及中文版本,均受版权保护,未经授权严禁转载、翻译或发布。如有疑问或合作需求,请联系邮箱:asimovpresschina@163.com。
Copyright © 2024 Asimov Press

>登录 press.asimov.com 输入邮箱成为订阅会员<






































